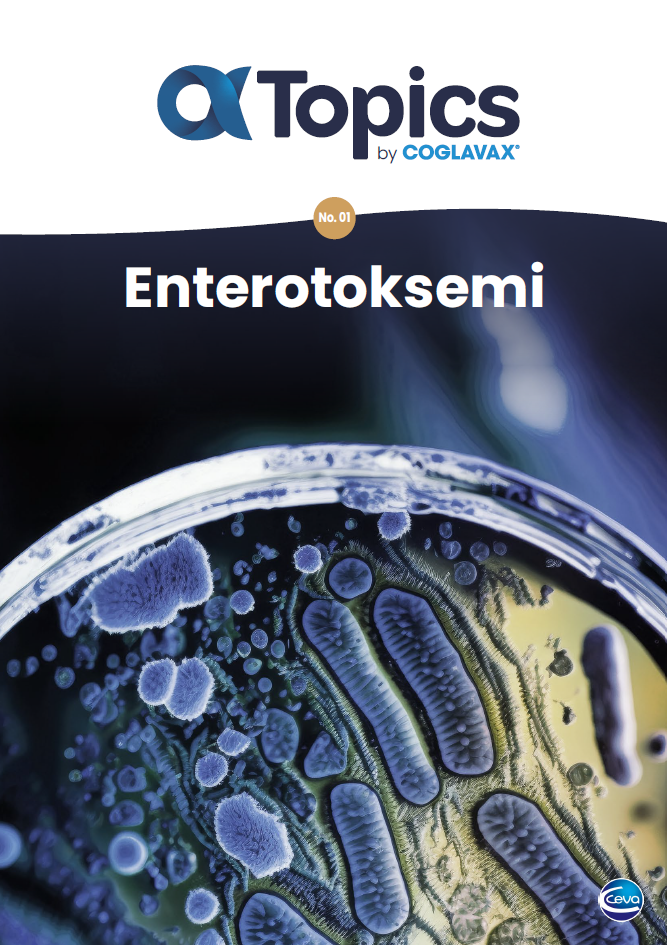
Alfa topics by Coglavax Enterotoksemi

Bu e-kitapta şunları bulacaksın…
-
Enterotoksemi (çelerme) etiyolojisi hakkında bilgiler,
-
Clostridium perfringens alfa toksininin salgın patogenezindeki rolü,
-
Enterotoksemi patogenezi, klinik belirtileri, anatomik ve patolojik bulguları, post-mortem tanı hakkında bilgiler...
Daha fazlasını öğrenmek mi istiyorsun?
Enterotoksemi hakkında kapsamlı bilgi edinip ruminantlarda görülen enterotoksemi salgınlarının çoğunluğunun patogenezinde önemli rol alan α-toksin (Toksin A)'i yakından tanımak için kitabı indirin!
📩 Üstelik indirmek çok kolay!